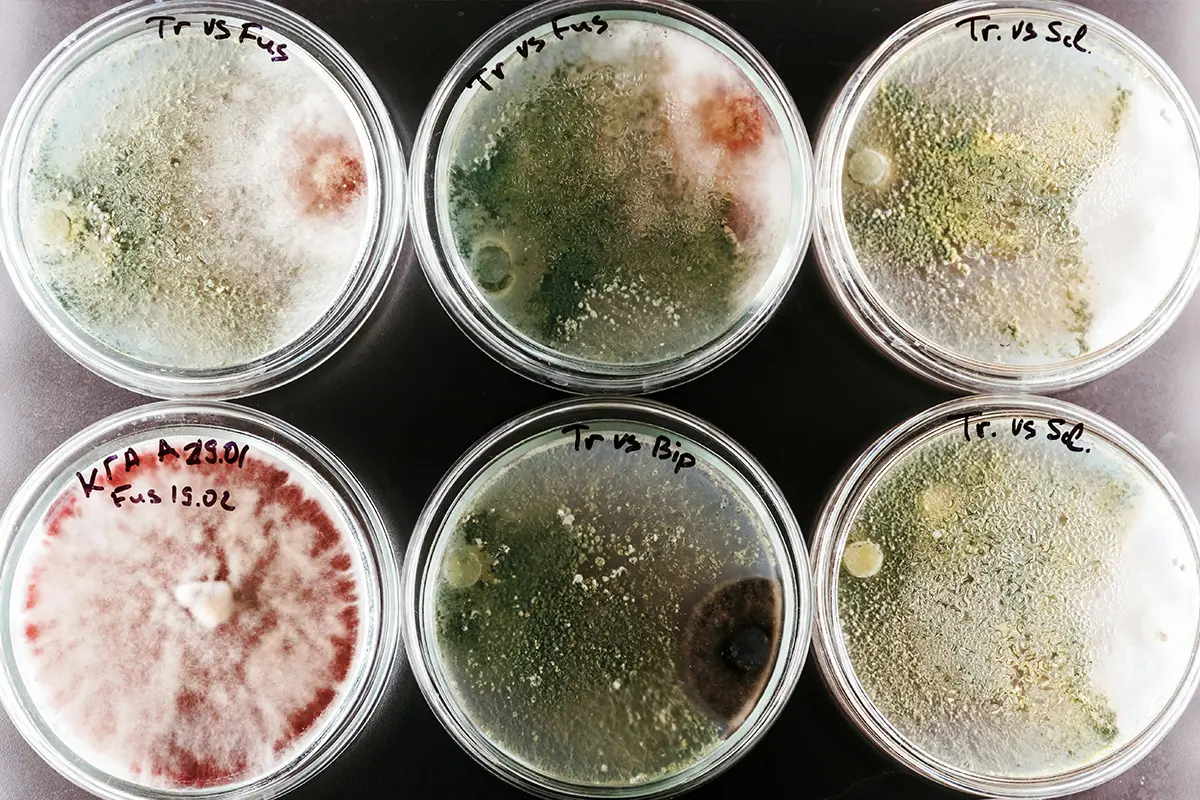

Serological Pipettes
Get reliable quality in a low-cost serological pipette. Set a regular order schedule and never think about it again. It’s one less thing on your mind.

Less hassle with inventory

Fewer contamination concerns
 Stay within budget
Stay within budget
 Reduce supplier complexity
Reduce supplier complexity
 Avoid supply shortages
Avoid supply shortages
 Make your job easier
Make your job easier

Less hassle with inventory

Fewer contamination concerns
 Stay within budget
Stay within budget
 Reduce supplier complexity
Reduce supplier complexity
 Avoid supply shortages
Avoid supply shortages
 Make your job easier
Make your job easier
Why get your serological pipettes from us?
When you order serological pipettes from Scilogex, you get more than a lab essential. You get simplicity and reliability, so you can focus on running your lab without getting bogged down in supplier issues. Here’s what you can expect:
Reduce supplier complexity
Get everything you need from one trusted source, cutting down on supplier management and streamlining your orders.
Never receive a shipment of lemons
Manufactured to high standards, our serological pipettes ensure reliable performance every time.
Get the packaging that suits your lab
Choose between bulk packs and individually wrapped pipettes to fit your lab’s storage and usage needs.
Reorder easily
Our support team is ready with quick answers, and reordering takes a couple clicks from your account.
Save budget by planning ahead
Take advantage of budget-friendly pricing on bulk orders to supply your lab for a longer stretch.
Where serological pipettes have an impact on the quality of your work
Serological pipettes play a vital role across dozens of tasks in the lab, making complex work more efficient and output more reliable.
Cell culture work
Maintain sterility and precision while transferring media, reagents, and cells - crucial for reliable cell growth and experimental results.

Microbiology and molecular biology
Prepare accurate dilutions and transfer samples confidently, ensuring contamination control and sample integrity.

Clinical labs
Handle patient samples and reagents for diagnostic tests smoothly and efficiently, helping maintain high-quality standards and prevent disruptions.

Biopharmaceutical research
Support the precise handling of small quantities in formulation and quality control processes, keeping tests consistent and dependable.

Environmental testing
Measure and transfer samples for soil, water, and air analysis accurately, ensuring the reliability of your test results.

Educational and research labs
Equip students and researchers with cost-effective, easy-to-use serological pipettes that support their learning and experiments at a manageable cost.
Where serological pipettes have an impact on the quality of your work
Serological pipettes play a vital role across dozens of tasks in the lab, making complex work more efficient and output more reliable.
Cell culture work
Maintain sterility and precision while transferring media, reagents, and cells - crucial for reliable cell growth and experimental results.

Microbiology and molecular biology
Prepare accurate dilutions and transfer samples confidently, ensuring contamination control and sample integrity.

Clinical labs
Handle patient samples and reagents for diagnostic tests smoothly and efficiently, helping maintain high-quality standards and prevent disruptions.

Biopharmaceutical research
Support the precise handling of small quantities in formulation and quality control processes, keeping tests consistent and dependable.

Environmental testing
Measure and transfer samples for soil, water, and air analysis accurately, ensuring the reliability of your test results.

Educational and research labs
Equip students and researchers with cost-effective, easy-to-use serological pipettes that support their learning and experiments at a manageable cost.
Get 7 serological pipette features that make your job less challenging
1. Bi-directional graduations for easy, precise measurements. Clear markings on both sides of the pipette help ensure accurate liquid handling at a glance.
2. Aerosol barrier plugs for contamination prevention. Each pipette is fitted with an aerosol barrier plug to protect against sample contamination and maintain a sterile workflow.
3. Optically clear polystyrene construction. Made from high-quality, transparent polystyrene for durability and visibility during use.
4. Precision calibration within ±2%. Every pipette is calibrated to stringent accuracy standards, so you can trust your measurements for critical applications.
1. Bi-directional graduations for easy, precise measurements. Clear markings on both sides of the pipette help ensure accurate liquid handling at a glance.
2. Aerosol barrier plugs for contamination prevention. Each pipette is fitted with an aerosol barrier plug to protect against sample contamination and maintain a sterile workflow.
3. Optically clear polystyrene construction. Made from high-quality, transparent polystyrene for durability and visibility during use.
4. Precision calibration within ±2%. Every pipette is calibrated to stringent accuracy standards, so you can trust your measurements for critical applications.
5. Gamma-irradiated for guaranteed sterility. Sterilized through gamma irradiation, ensuring that each pipette is safe and ready for immediate use.
6. RNase, DNase, and DNA-free. Certified free from RNase, DNase, and DNA to protect sensitive experiments from unwanted contamination.
7. Non-pyrogenic properties. Tested to be non-pyrogenic, making these pipettes safe for handling materials in research and clinical environments where safety is crucial.
5. Gamma-irradiated for guaranteed sterility. Sterilized through gamma irradiation, ensuring that each pipette is safe and ready for immediate use.
6. RNase, DNase, and DNA-free. Certified free from RNase, DNase, and DNA to protect sensitive experiments from unwanted contamination.
7. Non-pyrogenic properties. Tested to be non-pyrogenic, making these pipettes safe for handling materials in research and clinical environments where safety is crucial.
Need to supplement your pipette pumps with additional tools?
Most labs use multiple instruments for various SOPs. Get everything you need in a single order and reduce the logistical burden of keeping your lab supplied.

Electronic pipette controllers

Manual pipettors

Motorized pipette fillers
Frequently asked questions about serological pipettes
Serological pipettes are versatile tools used for accurately measuring and transferring liquids in labs. Common applications include cell culture work, sample preparation, and solution transfers in research, clinical, and educational settings.
Yes, serological pipettes are designed to work with most standard pipette controllers, making them easy to integrate into your existing lab setup. This compatibility ensures seamless handling of different volumes without needing additional tools.
Serological pipettes often come individually wrapped and are sterilized via gamma irradiation. They feature aerosol barrier plugs that prevent both liquid and aerosols from contaminating pipette fillers or controllers, maintaining the sterility of your workflow.
Most high-quality serological pipettes, including those in our range, are made from optically clear polystyrene. This ensures durability and visibility during use, and they are certified RNase, DNase, DNA-free, and non-pyrogenic for sensitive lab applications.
Serological pipettes are precision-calibrated for accuracy within ±2%. This level of precision supports consistent measurements, essential for critical lab processes that require reliable results.
Absolutely. Serological pipettes are sterilized through gamma irradiation and are packed in a Class 100,000 clean room, ensuring they meet high sterility standards suitable for research and clinical use.
Yes, serological pipettes come in a variety of sizes, ranging from 1ml to 50ml, to support a wide range of lab tasks and volume requirements. This variety helps reduce the need for multiple types of pipettes in the lab, simplifying inventory.

10x10, 30L, up to 500°C. The Hotplate Stirrer you need.

Save time, Save money, and save valuable chemicals. It's genie-us.

Trade in your old pipettes today for a major discount toward the new Superpette.
Do you have any product inquiries or other concerns?
Let us know or ask anything by filling out the form below. One of our laboratory equipment experts will get back to you within 24 hours
For more information please
call +1 (860) 436-9221
or email us at [email protected]
Why Buy From SCILOGEX?

Scilogex only guarantees quality and excellence. Serving laboratories for all areas of research for many years already, we offer a wide range of innovative benchtop equipment designed to meet requirements and budget of virtually any laboratory. Operate at your highest level of efficiency with our advanced line of liquid handling and laboratory products manufactured by our partners in ISO90001 facilities and are UL approved with cTUVus and cSAus certifications.
Always customer-focused, we make sure our patrons are given the best deals, warranties, and customer service in the market. Trust our laboratory experts to provide not just exceptional pre-purchase support but also unparalleled product recommendations.
View our 2025 Product Catalog
Get our complete and latest product portfolio for free.
Earn Rewards
Enjoy exclusive deals & discounts on our lab equipment & supplies.
Download Scilogex Literature
Find a collection of product manuals and brochure PDFs available for download.